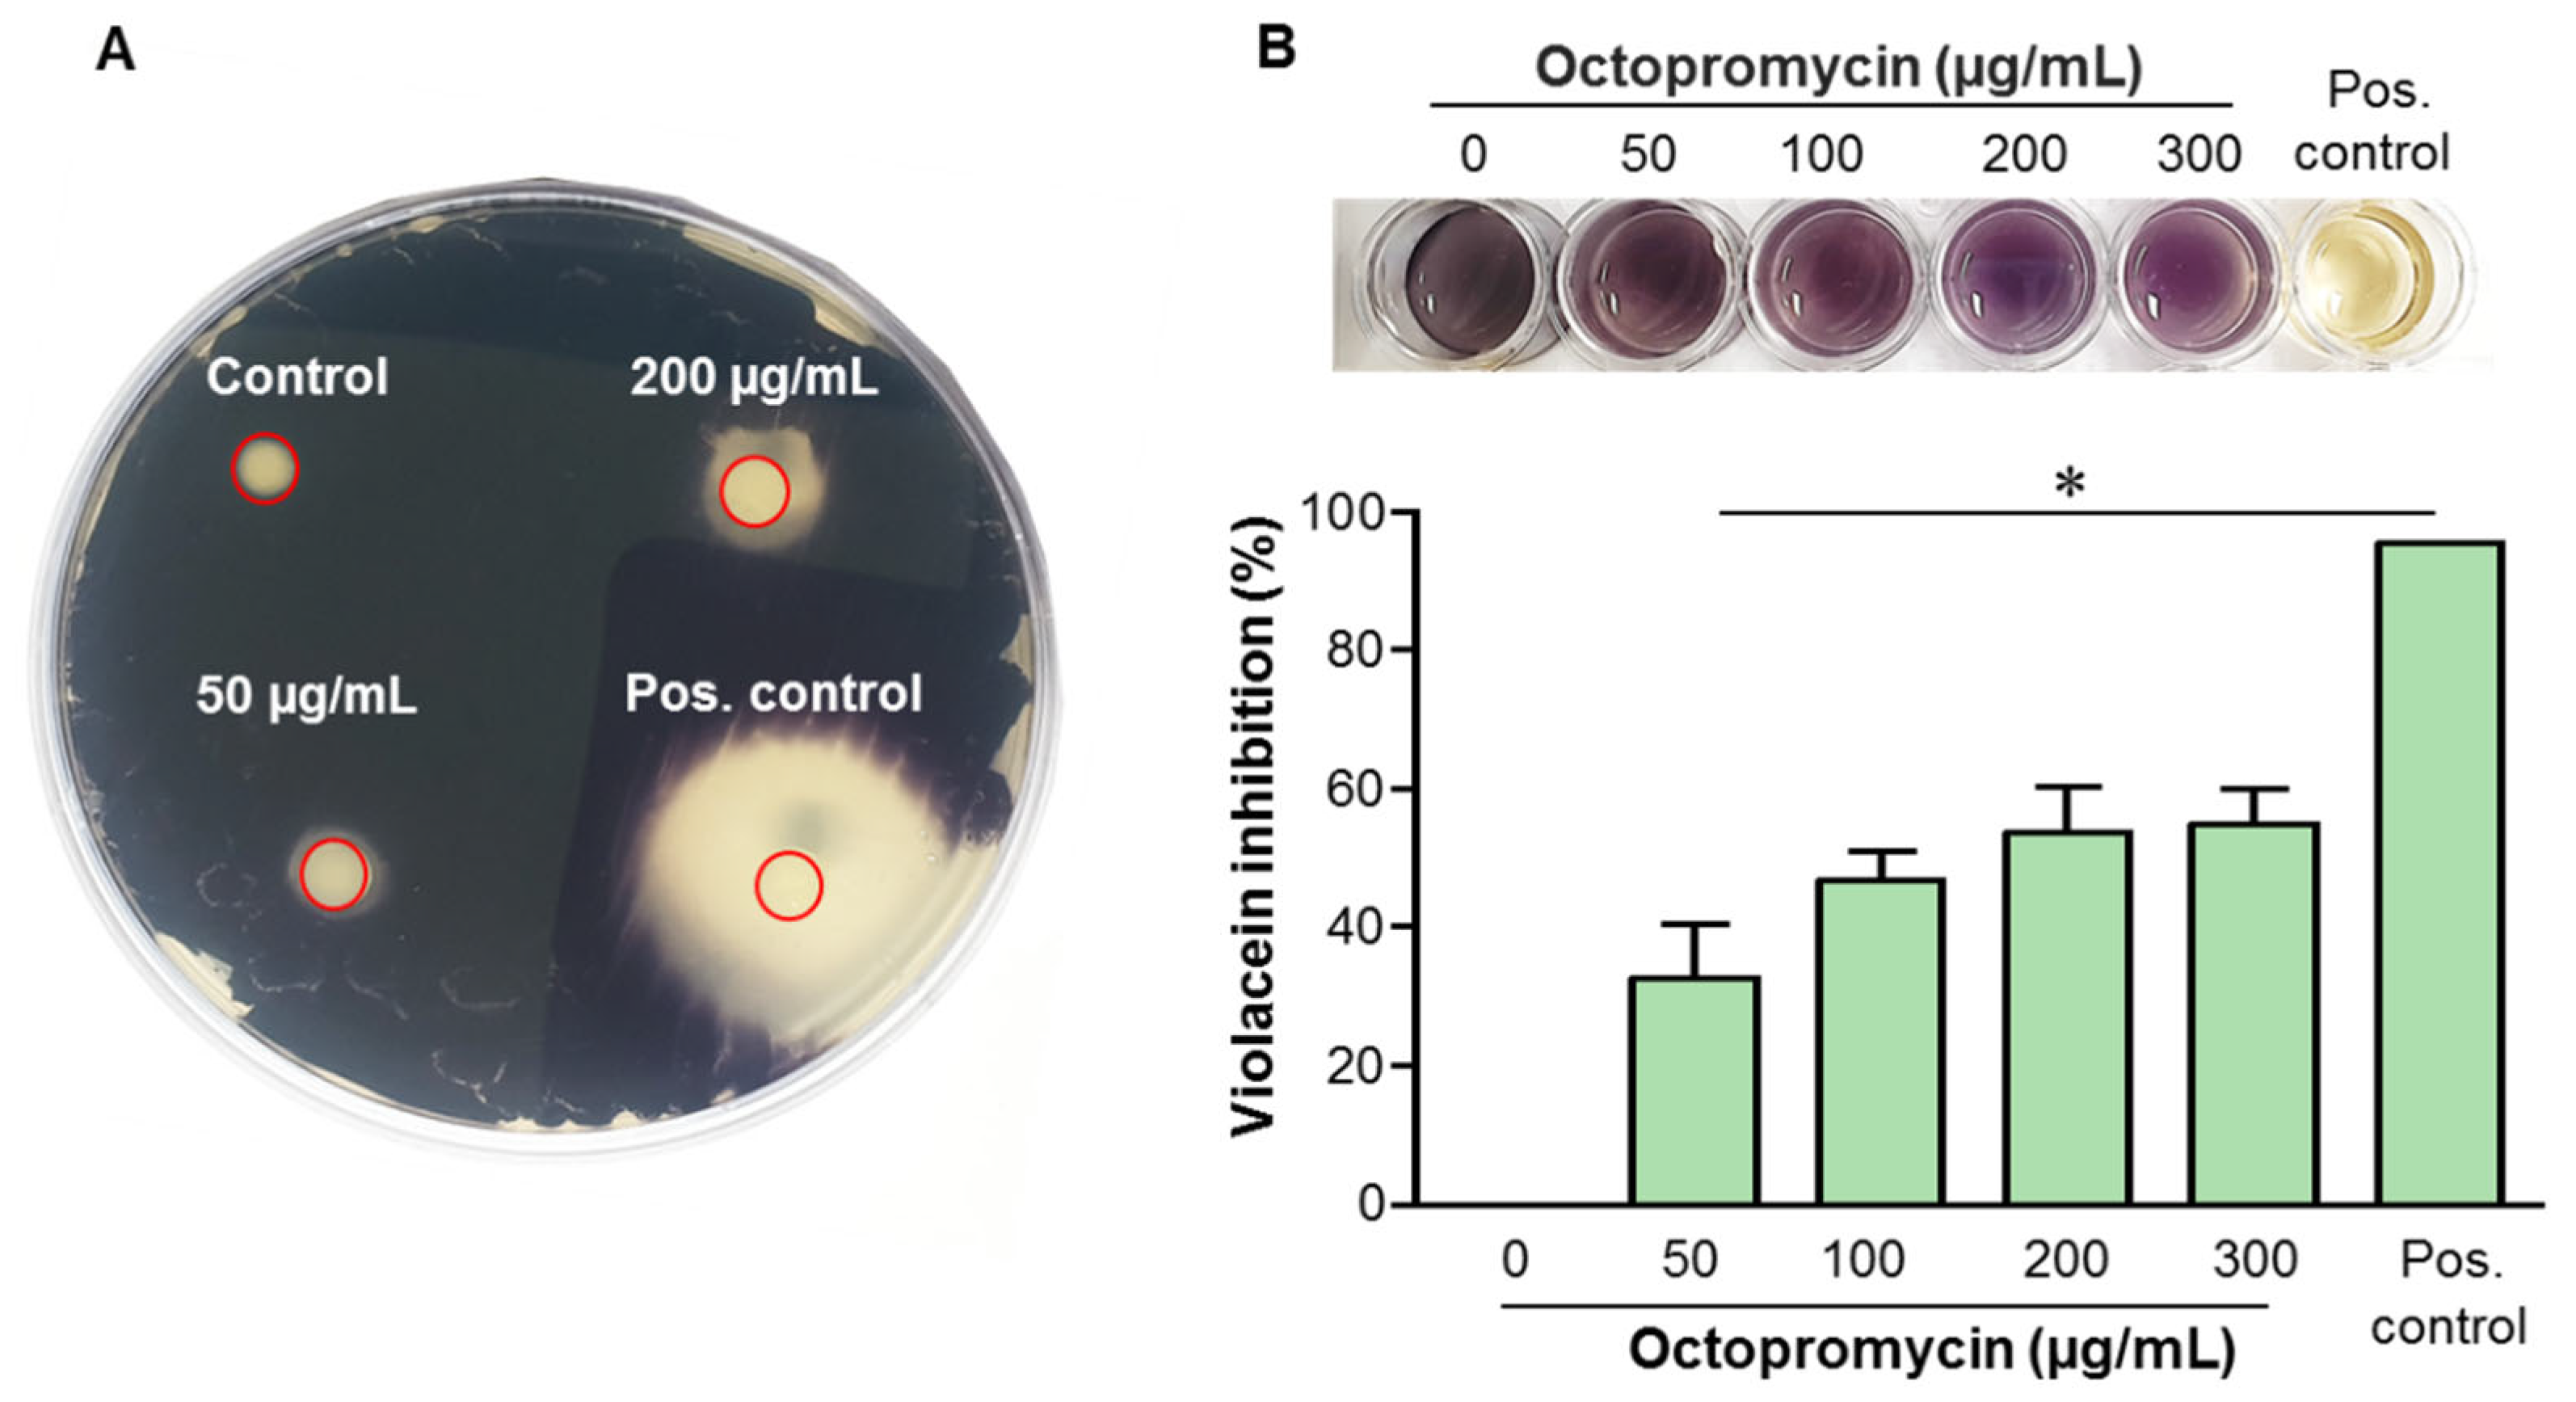
Antibiotics 12 00623 g003 Antibiotics 12 00623 g003

The Antimicrobial Peptide Octopromycin Suppresses Biofilm Formation and Quorum Sensing in Acinetobacter baumannii
Abstract
1. Introduction
2. Results
2.1. Octopromycin Inhibits and Eradicates A. baumannii Biofilms
2.2. Octopromycin Destroys A. baumannii Biofilm Structure
2.3. Inhibitory Effect of Octopromycin on Persister A. baumannii and Alginate Production
2.4. Octopromycin Inhibits QS in C. violaceum
2.5. Octopromycin Decreases Surface and Twitching Motility of A. baumannii
3. Discussion
4. Materials and Methods
4.1. Bacterial Identification and Culture Conditions
4.2. Determination of MBIC and MBEC
4.3. FE-SEM Analysis
4.4. Effect of Octopromycin on Inhibition of A. baumannii Persisters
4.5. QS Inhibition Bioassay in C. violaceum
4.6. Effect of Octopromycin on Alginate Production in A. baumannii
4.7. Effect of Octopromycin on Swimming, Swarming, and Twitching Motility of A. baumannii
4.8. Statistical Analysis
5. Conclusions
Author Contributions
Funding
Institutional Review Board Statement
Informed Consent Statement
Data Availability Statement
Conflicts of Interest
References
- Nocera, F.P.; Attili, A.R.; De Martino, L. Acinetobacter baumannii: Its Clinical Significance in Human and Veterinary Medicine. Pathogens 2021, 10, 127. [Google Scholar] [CrossRef] [PubMed]
- Moubareck, C.A.; Halat, D.H. Insights into Acinetobacter baumannii: A Review of Microbiological, Virulence, and Resistance Traits in a Threatening Nosocomial Pathogen. Antibiotics 2020, 09, 119. [Google Scholar] [CrossRef] [PubMed]
- Peleg, A.Y.; Seifert, H.; Paterson, D.L. Acinetobacter baumannii: Emergence of a Successful Pathogen. Clin. Microbiol. Rev. 2008, 21, 538–582. [Google Scholar] [CrossRef] [PubMed]
- Verstraeten, N.; Braeken, K.; Debkumari, B.; Fauvart, M.; Fransaer, J.; Vermant, J.; Michiels, J. Living on a Surface: Swarming and Biofilm Formation. Trends Microbiol. 2008, 16, 496–506. [Google Scholar] [CrossRef]
- Jamal, M.; Ahmad, W.; Andleeb, S.; Jalil, F.; Imran, M.; Nawaz, M.A.; Hussain, T.; Ali, M.; Rafiq, M.; Kamil, M.A. Bacterial Biofilm and Associated Infections. J. Chin. Med. Assoc. 2018, 81, 7–11. [Google Scholar] [CrossRef] [PubMed]
- Lyczak, J.B.; Cannon, C.L.; Pier, G.B. Lung infections associated with cystic fibrosis. Microbiol. Rev. 2002, 15, 194–222. [Google Scholar] [CrossRef]
- Hojo, K.; Nagaoka, S.; Ohshima, T.; Maeda, N. Critical Review in Oral Biology & Medicine: Bacterial Interactions in Dental Biofilm Development. J. Dent. Res. 2009, 88, 982–990. [Google Scholar] [CrossRef] [PubMed]
- Holá, V.; Ruzicka, F.; Horka, M. Microbial Diversity in Biofilm Infections of the Urinary Tract with the Use of Sonication Techniques. FEMS Immunol. Med. Microbiol. 2010, 59, 525–528. [Google Scholar] [CrossRef]
- Trampuz, A.; Zimmerli, W. Prosthetic Joint Infections: Update in Diagnosis and Treatment. Swiss Med. Wkly. 2005, 135, 17–18, 243–251. [Google Scholar] [PubMed]
- Lerche, C.J.; Schwartz, F.; Theut, M.; Fosbøl, E.L.; Iversen, K.; Bundgaard, H.; Høiby, N.; Moser, C. Anti-Biofilm Approach in Infective Endocarditis Exposes New Treatment Strategies for Improved Outcome. Front. Cell Dev. Biol. 2021, 9, 643335. [Google Scholar] [CrossRef]
- Stewart, P.S. Antimicrobial Tolerance in Biofilms Examples of Reduced Biofilm Susceptibility. Microbiol. Spectr. 2015, 3, 1532. [Google Scholar] [CrossRef] [PubMed]
- Liu, W.; Wu, Z.; Mao, C.; Guo, G.; Zeng, Z.; Fei, Y.; Wan, S.; Peng, J.; Wu, J. Antimicrobial Peptide Cec4 Eradicates the Bacteria of Clinical Carbapenem-Resistant Acinetobacter baumannii Biofilm. Front. Microbiol. 2020, 11, 1532. [Google Scholar] [CrossRef]
- Rabin, N.; Zheng, Y.; Opoku-Temeng, C.; Du, Y.; Bonsu, E.; Sintim, H.O. Biofilm Formation Mechanisms and Targets for Developing Antibiofilm Agents. Future Med. Chem. 2015, 7, 493–512. [Google Scholar] [CrossRef] [PubMed]
- Zhang, L.H.; Dong, Y.H. Quorum Sensing and Signal Interference: Diverse Implications. Mol. Microbiol. 2004, 53, 1563–1571. [Google Scholar] [CrossRef] [PubMed]
- Yarwood, J.M.; Bartels, D.J.; Volper, E.M.; Greenberg, E.P. Quorum Sensing in Staphylococcus aureus Biofilms. J. Bacteriol. 2004, 186, 1838–1850. [Google Scholar] [CrossRef]
- Ling, J.; Zhou, L.; Wu, G.; Zhao, Y.; Jiang, T.; Liu, F. The AHL Quorum-Sensing System Negatively Regulates Growth and Autolysis in Lysobacter brunescens. Front. Microbiol. 2019, 10, 2748. [Google Scholar] [CrossRef]
- Asfour, H.Z. Anti—Quorum Sensing Natural Compounds. J. Microsc. Ultrastruct. 2018, 6, 1. [Google Scholar] [CrossRef]
- Nait Chabane, Y.; Mlouka, M.B.; Alexandre, S.; Nicol, M.; Marti, S.; Pestel-Caron, M.; Vila, J.; Jouenne, T.; Dé, E. Virstatin Inhibits Biofilm Formation and Motility of Acinetobacter baumannii. BMC Microbiol. 2014, 14, 62. [Google Scholar] [CrossRef]
- Lewies, A.; Du Plessis, L.H.; Wentzel, J.F. Antimicrobial Peptides: The Achilles’ Heel of Antibiotic Resistance? Probiotics Antimicrob. Proteins 2019, 11, 370–381. [Google Scholar] [CrossRef]
- Lee, J.-K.; Park, S.; Kim, Y.-M.; Guk, T.; Lee, M.-Y.; Park, S.-C.; Lee, J.R.; Jang, M.-K. Candidacidal and Antibiofilm Activity of PS1-3 Peptide against Drug-Resistant Candida albicans on Contact Lenses. Pharmaceutics 2022, 14, 1602. [Google Scholar] [CrossRef]
- Pfalzgraff, A.; Brandenburg, K.; Weindl, G. Antimicrobial Peptides and Their Therapeutic Potential for Bacterial Skin Infections and Wounds. Front. Pharmacol. 2018, 9, 281. [Google Scholar] [CrossRef]
- Raheem, N.; Straus, S.K. Mechanisms of Action for Antimicrobial Peptides With Antibacterial and Antibiofilm Functions. Front. Microbiol. 2019, 10, 2866. [Google Scholar] [CrossRef] [PubMed]
- Neshani, A.; Sedighian, H.; Mirhosseini, S.A.; Ghazvini, K.; Zare, H.; Jahangiri, A. Antimicrobial Peptides as a Promising Treatment Option against Acinetobacter baumannii Infections. Microb. Pathog. 2020, 146, 104238. [Google Scholar] [CrossRef] [PubMed]
- Rajapaksha, D.C.; Jayathilaka, E.H.T.T.; Edirisinghe, S.L.; Nikapitiya, C.; Lee, J.; Whang, I.; De Zoysa, M. Octopromycin: Antibacterial and Antibiofilm Functions of a Novel Peptide Derived from Octopus Minor against Multidrug-Resistant Acinetobacter baumannii. Fish Shellfish Immunol. 2021, 117, 82–94. [Google Scholar] [CrossRef] [PubMed]
- Bai, J.R.; Wu, Y.P.; Elena, G.; Zhong, K.; Gao, H. Insight into the Effect of Quinic Acid on Biofilm Formed by Staphylococcus aureus. RSC Adv. 2019, 9, 3938–3945. [Google Scholar] [CrossRef]
- Gopu, V.; Meena, C.K.; Shetty, P.H. Quercetin Influences Quorum Sensing in Food Borne Bacteria: In-Vitro and In-Silico Evidence. PLoS ONE 2015, 10, e0134684. [Google Scholar] [CrossRef]
- Vijayakumar, S.; Rajenderan, S.; Laishram, S.; Anandan, S.; Balaji, V.; Biswas, I. Biofilm Formation and Motility Depend on the Nature of the Acinetobacter baumannii Clinical Isolates. Front. Public Health 2016, 4, 105. [Google Scholar] [CrossRef]
- Macià, M.D.; Rojo-Molinero, E.; Oliver, A. Antimicrobial Susceptibility Testing in Biofilm-Growing Bacteria. Clin. Microbiol. Infect. 2014, 20, 981–990. [Google Scholar] [CrossRef]
- Roy, R.; Tiwari, M.; Donelli, G.; Tiwari, V. Strategies for Combating Bacterial Biofilms: A Focus on Anti-Biofilm Agents and Their Mechanisms of Action. Virulence 2018, 9, 522–554. [Google Scholar] [CrossRef]
- Zeng, P.; Yi, L.; Xu, J.; Gao, W.; Xu, C.; Chen, S.; Chan, K.F.; Wong, K.Y. Bioactivity and Bactericidal Mechanism of Histidine-Rich β-Hairpin Peptide against Gram-Negative Bacteria. Biochim. Biophys. Acta—Biomembr. 2021, 9, 4755–4761. [Google Scholar]
- Ramalingam, K.; Lee, V.A. Antibiofilm Activity of an EDTA-Containing Nanoemulsion on Multidrug-Resistant Acinetobacter baumannii. Artif. Cells Nanomed. Biotechnol. 2018, 46, 737–743. [Google Scholar] [CrossRef] [PubMed]
- Mwangi, J.; Yin, Y.; Wang, G.; Yang, M.; Li, Y.; Zhang, Z.; Lai, R. The Antimicrobial Peptide ZY4 Combats Multi Drug resistant Pseudomonas Aeruginosa and Acinetobacter baumannii Infection. Proc. Natl. Acad. Sci. USA 2019, 116, 26516–26522. [Google Scholar] [CrossRef] [PubMed]
- Wong, F.H.; Cai, Y.; Leck, H.; Lim, T.P.; Teo, J.Q.; Lee, W.; Koh, T.H.; Tan, T.T.; Tan, K.W.; Kwa, A.L. Determining the Development of Persisters in Extensively Drug-Resistant Acinetobacter baumannii upon Exposure to Polymyxin B-Based Antibiotic Combinations Using Flow Cytometry. Antimicrob. Agents Chemother. 2020, 64, e01712-19. [Google Scholar] [CrossRef] [PubMed]
- Hazan, R.; Maura, D.; Que, Y.A.; Rahme, L.G. Assessing Pseudomonas aeruginosa Persister/antibiotic tolerant cells. Methods Mol. Biol. 2014, 1149, 699–707. [Google Scholar] [CrossRef] [PubMed]
- Lewis, K. Persister Cells. Annu. Rev. Microbiol. 2010, 64, 357–372. [Google Scholar] [CrossRef] [PubMed]
- Grassi, L.; Di Luca, M.; Maisetta, G.; Rinaldi, A.C.; Esin, S.; Trampuz, A.; Batoni, G. Generation of Persister Cells of Pseudomonas Aeruginosa and Staphylococcus Aureus by Chemical Treatment and Evaluation of Their Susceptibility to Membrane-Targeting Agents. Front. Microbiol. 2017, 8, 1917. [Google Scholar] [CrossRef]
- Davenport, E.K.; Call, D.R.; Beyenal, H. Differential Protection from Tobramycin by Extracellular Polymeric Substances from Acinetobacter baumannii and Staphylococcus aureus Biofilms. Antimicrob. Agents Chemother. 2014, 58, 4755–4761. [Google Scholar] [CrossRef]
- Saipriya, K.; Swathi, C.H.; Ratnakar, K.S.; Sritharan, V. Quorum-Sensing System in Acinetobacter baumannii: A Potential Target for New Drug Development. J. Appl. Microbiol. 2020, 128, 15–27. [Google Scholar] [CrossRef]
- Ma, Z.P.; Song, Y.; Cai, Z.H.; Lin, Z.J.; Lin, G.H.; Wang, Y.; Zhou, J. Anti-Quorum Sensing Activities of Selected Coral Symbiotic Bacterial Extracts from the South China Sea. Front. Cell. Infect. Microbiol. 2018, 8, 144. [Google Scholar] [CrossRef]
- Hooshdar, P.; Kermanshahi, R.K.; Ghadam, P.; Khosravi-Darani, K. A Review on Production of Exopolysaccharide and Biofilm in Probiotics like Lactobacilli and Methods of Analysis. Biointerface Res. Appl. Chem. 2020, 10, 6058–6075. [Google Scholar] [CrossRef]
- Singh, B.R.; Singh, V.; Ebibeni, N.; Singh, R.K. Antimicrobial and Herbal Drug Resistance in Enteric Bacteria Isolated from Faecal Droppings of Common House Lizard/Gecko (Hemidactylus frenatus). Int. J. Microbiol. 2013, 2013, 340848. [Google Scholar] [CrossRef] [PubMed]
- Kothari, V.; Sharma, S.; Padia, D. Recent Research Advances on Chromobacterium violaceum. Asian Pac. J. Trop. Med. 2017, 10, 744–752. [Google Scholar] [CrossRef] [PubMed]
- Vasavi, H.S.; Arun, A.B.; Rekha, P.D. Inhibition of Quorum Sensing in Chromobacterium violaceum by Syzygium cumini L. and FPimenta dioica L. Asian Pac. J. Trop. Biomed. 2013, 3, 954–959. [Google Scholar] [CrossRef] [PubMed]
- Vásquez-Ponce, F.; Higuera-Llantén, S.; Pavlov, M.S.; Ramírez-Orellana, R.; Marshall, S.H.; Olivares-Pacheco, J. Alginate Overproduction and Biofilm Formation by Psychrotolerant Pseudomonas mandelii Depend on Temperature in Antarctic Marine Sediments. Electron. J. Biotechnol. 2017, 28, 27–34. [Google Scholar] [CrossRef]
- Boyd, A.; Chakrabarty, A.M. Pseudomonas aeruginosa biofilms: Role of the alginate exopolysaccharide. J. Ind. Microbiol. 1995, 15, 162–168. [Google Scholar] [CrossRef]
- Dong, N.; Wang, C.; Zhang, T.; Zhang, L.; Xue, C.; Feng, X.; Bi, C.; Shan, A. Bioactivity and Bactericidal Mechanism of Histidine-Rich β-Hairpin Peptide against Gram-Negative Bacteria. Int. J. Mol. Sci. 2019, 20, 3954. [Google Scholar] [CrossRef]
- Topa, S.H.; Subramoni, S.; Palombo, E.A.; Kingshott, P.; Rice, S.A.; Blackall, L.L. Cinnamaldehyde Disrupts Biofilm Formation and Swarming Motility of Pseudomonas aeruginosa. Microbiology 2018, 164, 1087–1097. [Google Scholar] [CrossRef]
- Zhong, S.; He, S. Quorum Sensing Inhibition or Quenching in Acinetobacter baumannii: The Novel Therapeutic Strategies for New Drug Development. Front. Microbiol. 2021, 12, 558003. [Google Scholar] [CrossRef]
- Gholami, M.; Zeighami, H.; Bikas, R.; Heidari, A.; Rafiee, F.; Haghi, F. Inhibitory Activity of Metal-Curcumin Complexes on Quorum Sensing Related Virulence Factors of Pseudomonas aeruginosa PAO1. AMB Express 2020, 10, 111. [Google Scholar] [CrossRef]

Disclaimer/Publisher’s Note: The statements, opinions and data contained in all publications are solely those of the individual author(s) and contributor(s) and not of MDPI and/or the editor(s). MDPI and/or the editor(s) disclaim responsibility for any injury to people or property resulting from any ideas, methods, instructions or products referred to in the content. |
© 2023 by the authors. Licensee MDPI, Basel, Switzerland. This article is an open access article distributed under the terms and conditions of the Creative Commons Attribution (CC BY) license (https://creativecommons.org/licenses/by/4.0/).
Share and Cite
Rajapaksha, D.C.; Edirisinghe, S.L.; Nikapitiya, C.; Whang, I.; De Zoysa, M. The Antimicrobial Peptide Octopromycin Suppresses Biofilm Formation and Quorum Sensing in Acinetobacter baumannii. Antibiotics 2023, 12, 623. https://doi.org/10.3390/antibiotics12030623
Rajapaksha DC, Edirisinghe SL, Nikapitiya C, Whang I, De Zoysa M. The Antimicrobial Peptide Octopromycin Suppresses Biofilm Formation and Quorum Sensing in Acinetobacter baumannii. Antibiotics. 2023; 12(3):623. https://doi.org/10.3390/antibiotics12030623
Chicago/Turabian StyleRajapaksha, Dinusha Chathurangi, Shan Lakmal Edirisinghe, Chamilani Nikapitiya, Ilson Whang, and Mahanama De Zoysa. 2023. "The Antimicrobial Peptide Octopromycin Suppresses Biofilm Formation and Quorum Sensing in Acinetobacter baumannii" Antibiotics 12, no. 3: 623. https://doi.org/10.3390/antibiotics12030623
APA StyleRajapaksha, D. C., Edirisinghe, S. L., Nikapitiya, C., Whang, I., & De Zoysa, M. (2023). The Antimicrobial Peptide Octopromycin Suppresses Biofilm Formation and Quorum Sensing in Acinetobacter baumannii. Antibiotics, 12(3), 623. https://doi.org/10.3390/antibiotics12030623

